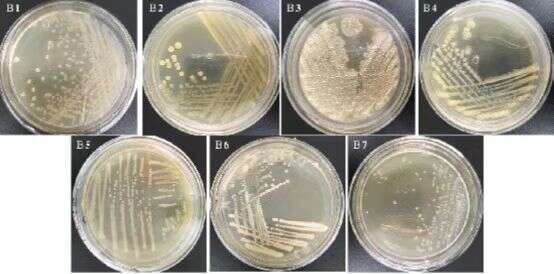

中青报·中青网见习记者 杨洁
这是一个色香俱全的实验室。
在一个个燕麦培养基中加入金属离子,燕麦味道一会儿便飘香了半个屋子,这是“北工商”链霉菌最喜欢的生存环境;在另一个培养皿里,被分离出来的单孢哈萨克斯坦酵母菌会散发出清香的气味,呈现出圆形小颗粒形状;而被加入了“北工商”海洋杆菌的培养液中,液体颜色则逐渐变为黄酒的焦糖色。
“各种白酒的酒曲、窖池和酿造环境,形成了一个个独特的微生物资源库,含有大量的未知菌种,这些菌种是我国特有的、宝贵的微生物资源。它们有哪些生物学功能?如何酿造出美酒的?这些亟待我们展开研究和开发利用。”
在长达10年的时间,北京工商大学轻工科学技术学院副教授任清带领团队,从我国传统白酒酒曲、酒醅和窖泥中分离筛选酿酒微生物86个属,3000余株细菌,其中,已经鉴定确认细菌新种24种,大部分用“北工商”和“北京”命名,他们正一步步解开藏在酒香的神秘“群落”。
酿酒微生物在培养皿中显现。受访者供图
微生物是传统酿酒工艺的“芯片”
对于1996年出生的姑娘刘波来说,白酒、黄酒等名词原本跟她的生活并不相关。但跟着课题组展开两年多的研究后,每逢过年,这位研三的学生会在饭桌上跟父亲一一科普,指着其中一瓶分辨是浓香型白酒还是清香型白酒,这背后到底是什么微生物在起作用。
在微观的世界里,中国传统酿酒是依靠微生物发酵而生产。而在这一条肉眼不可见的“生产链”上,多个微生物菌种正有条不紊地分工合作着:当人们把酿酒原料和酒曲倒入窖池,根霉和曲霉等霉菌会加速淀粉变成葡萄糖,酵母菌又将葡萄糖转化为乙醇。醋酸杆菌接过下一个生产线,促进葡萄糖变成乙酸,乙酸再经过多种微生物的酯化作用生成乙酸乙酯,多种微生物协力合作,也就初步完成了清香型白酒的酿造。
“国外酒风味单一,其酿酒主要是单菌种或少数菌种的液态发酵技术,微生物种类少,所以,发酵形成的风味物质少。而我国白酒酿造是自然多菌种固态发酵,有着独特的酿造工艺,靠着几百年传承下来的制曲技术和老窖池,形成了一个独特的微生物资源库。”任清说。
以茅台、五粮液和汾酒的口味对比为例,三者之所以风味不同主要是因为其酿酒系统中微生物群体的差异化造成的。任清解释,如果要在其他地方酿出茅台的风味,就要破解茅台酿造系统中的微生物群落结构和多个微生物如何相互作用的难题。而当下传统酿酒行业过分依赖酿酒师和当地窖池,标准化程度低,受到地理气候和生态环境的影响,每一个窖池、每一批次酿造出来酒的品质也各不相同。
“如果能用科学的手段,找到了传统酿酒过程中是哪些功能微生物起主要作用,并分离这些主要的功能微生物,利用功能微生物就可以实现‘基于风味感知的白酒品质定向设计’。那么即便在北京也有可能生产出茅台,实现传统酿造向现代发酵工业生产的转变。”任清做了一个比喻,如果把传统酿酒工艺看作是一个系统,那么“芯片”就是微生物。
为了破解“芯片”的密码,从2013年开始,任清带领团队利用培养组学和高通量测序技术,从庞大的微生物生态系统中分离菌种,揭秘这一群藏在酒窖里的“群落”如何精密地运转。

北工商团队在实验室进行酿酒微生物实验。受访者供图
做科研并非每一天都有意思
在课题组里,刘波的工作是从庞大微生物生态系统里筛选菌种。她要从大量的样本里找到还没有被前人发现的微生物,像考古探险一样摸着黑往前走。
微生物的生存环境各不相同。在筛选菌种的过程中需要设置不同温度和pH值的培养基,待菌种生成后,纯化分离出来,展开筛选工作。对这个“95后”小姑娘来说,筛选菌种是一个“极其枯燥的过程”。
2020年5月,在一次菌种筛选工作中,她为每一个实验周期设计了360个培养皿,但养出来的微生物里都没有发现新的菌种。两个月的时间过去了,她的生活每天在做实验和看数据之间重复着。实验里使用的培养皿超过2000多个,堆积起来比这个身高175厘米左右的小姑娘还要高。
一天早上,刘波偶然发现之前的培养皿里长出了一个个形态幼小的微生物,不易被人察觉。她纯化分离出来,在显微镜下观察,经过鉴定发现是一株新菌,此后该株确定为拟杆菌属的一个新种。
发现新菌种的惊喜,王镓璇也曾亲眼见证过。那时她刚来课题组不久,正在埋头做实验,一个师姐突然从隔壁实验室里跑进来,高兴地叫起来,“我筛选出突变株了”。当时,实验室里所有的人都不约而同地停下来,为她鼓掌。后来王镓璇才知道,这位临近毕业的师姐已经为突变株筛选的问题死磕了两个月。
“做科研并非每一天都有意思,有时候需要多一点坚持和耐性。” 王镓璇说。
为何窖池里的微生物群落如此难以发现?任清解释,不同的菌种需要的培养基不同,生长速度不一致,有的长达三五天会长出形状,而有的则在第二天早上便已经养成。
但微生物菌种之间的相互作用关系非常复杂,有时单一菌种无法产生风味,而需要跟另一个菌种相互作用才能呈现出特定的性状。那么在实验之中要用生物信息学等知识展开关联性分析,摸索不同微生物之间潜在的“社交关系”。
王镓璇曾遇见一个顽固的微生物。当她在分离奇枝菌属的培养基上,曾发现培养基的表面意外地多出了裂痕。原本以为是因培养基的环境干燥出现了裂缝,可完成了多项对照试验后发现,每一组培养基里都有类似的裂痕。
这会不会是一种新的微生物?她把培养基的环境改成了液体,再提取基因组展开鉴定,惊奇地发现了新的微生物菌种。这一类菌种在固体培养基的环境里不会长在表面,而会嵌入到培养基之中,生长速度长达一周左右。
“做科研就是在枯燥和无趣之中坚持,要大胆地设想,不断地给出新的培养环境,总有一天会有收获的。” 跟着课题组完成了两年的研究,1998年出生的姑娘王镓璇慢慢学会了耐着性子做事。
私下里,任清常带着课题组的孩子们出去打打牙祭。但只要回到了实验室,这位教授对同学们的要求极为严格,他常说,“科研来不得半点虚假,工作一定要实打实地做,如果筛选出来好的微生物菌种,成果自然就出来了,但要是筛选不出来,不仅功夫白费了,甚至连毕业都够呛。”

北工商团队在实验室进行酿酒微生物实验。受访者供图
传统酿酒微生物库亟待开发
近十年的时间,任清课题组从我国传统白酒酒曲、酒醅和窖泥中分离筛选酿酒微生物86个属,3000余株细菌,其中,已经鉴定确认细菌新种24种,大部分用“北工商”和“北京”命名,目前正在鉴定70余新菌种,共计100余种微生物新菌种解开了神秘面纱。
“北工商”海洋杆菌是我国黄酒曲中发现的唯一新菌种。任清介绍,这个菌种可以合成番茄红素和类胡萝卜素等红色素,不仅可以作为黄酒重要的着色剂,代替焦糖色,还具备良好的抗氧化功能,可广泛应用在保健养生的产品中。
“‘北工商’食烷菌可以分解石油,生物分解无法降解的物质,对生态环境保护起到了一定的作用。‘北工商’节杆菌可以合成护肤成分,用于化妆品行业,”任清说,微生物的作用不仅仅在酿酒行业,通过一系列研究,未来在食品、护肤品等行业将会有广阔的应用前景。
除了单个微生物的作用,在微观世界里,微生物的“社交功能”可以产生化腐朽为神奇的力量。任清曾带着学生做过一组实验。当在进行降解人参皂苷的新菌种筛选中,用特殊培养基培育,过了几天,培养基会变成黑色。研究后才发现,“北工商”链霉菌在培养基之中会产生一种β-葡萄糖苷酶,使得葡萄糖苷键断裂,让人参和三七中的普通皂苷转化成药理活性更高的稀有皂苷,可以显著提高人参和三七的药用价值。
在研究中,团队发现部分微生物还承担着“唤醒”其他休眠状态菌种的工作,比如“北京”棒杆菌,它的一个基因编码一个特殊蛋白质,该蛋白质可以复苏休眠状态的细菌。他们克隆了该基因,正在研究该基因编码蛋白质的复苏功能。一旦应用到微生物培养中,可以促进微生物的“苏醒”,加速培育过程。如果应用到食品安全检测中,可以发现食品中潜伏的有害微生物。
10年间,围绕新菌种资源,团队开展了多项研究应用开发工作,获得授权国际发明专利2项,国家发明专利10项,获2021年中国轻工业联合会科技进步三等奖1项,其中,5项专利已经实现成果转化。
“酒香里藏着的微生物菌种是我国特有的微生物资源。”在任清看来,这个未知的“群落”还待进一步发现,“未来的工作是要建立我国酿酒微生物资源库,保护特有的菌种,让这一群在窖池里流传百年的“群落”可以真正地服务社会的发展。”